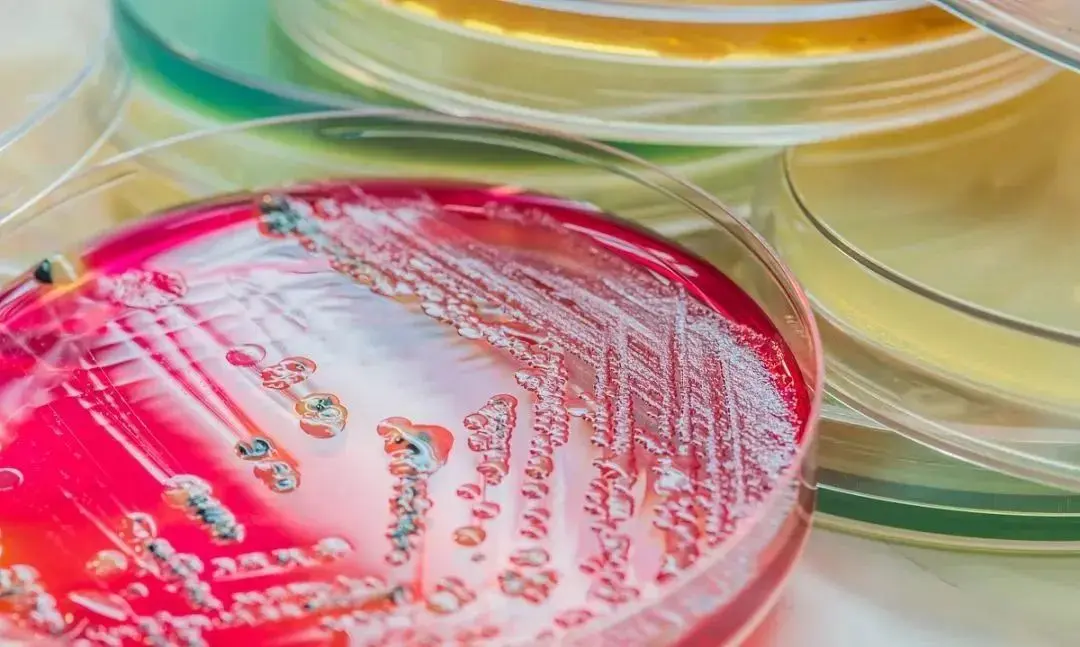
细胞培养基选择及检测
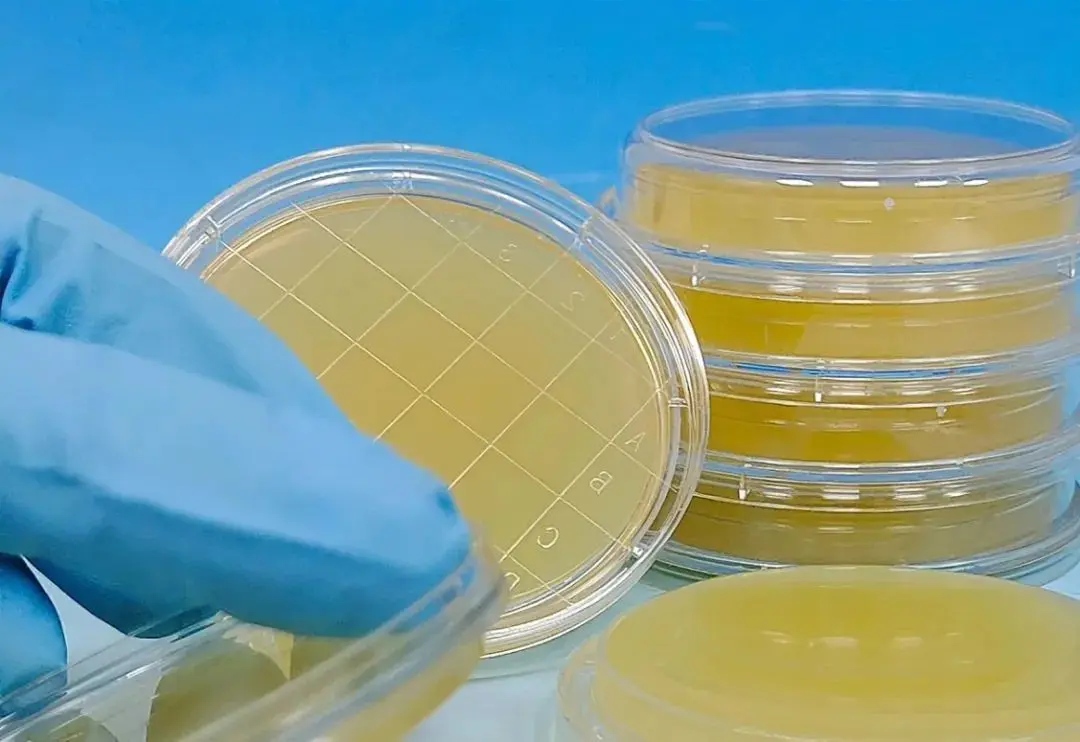
细胞培养基
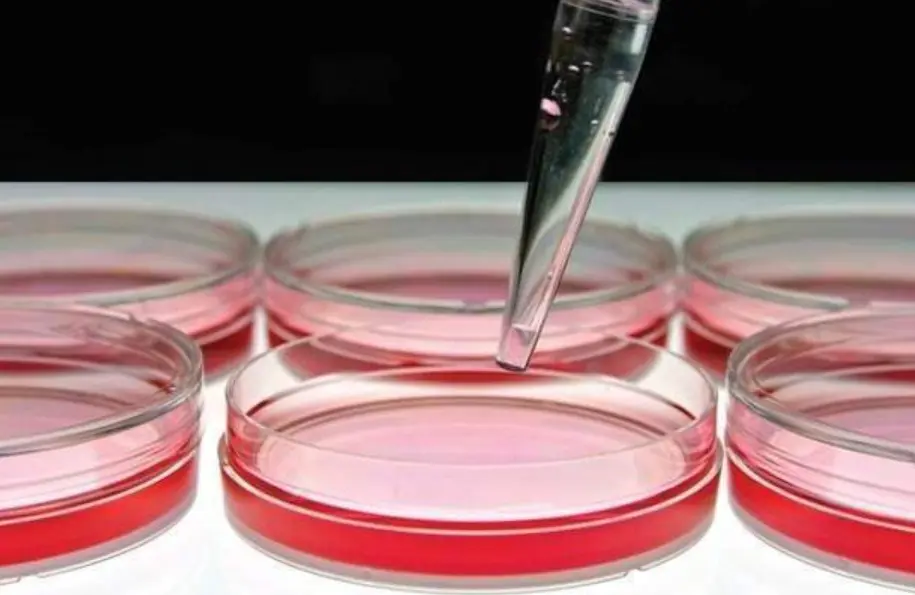
细胞培养基

生物制药的培养基选择及检测方法
发布时间:2025-12-29 浏览次数:3250
近几年随着我国生物医药的发展,行业市场需求增长稳定。培养基作为生物制品生产的重要原材料之一,其质量对生物制品有重要的影响。细胞培养基的生产工艺和细胞培养基的原材料选择、生产过程及检验过程中的质量控制对于细胞培养基的产品质量具有直接影响。
细胞培养基选择及检测
一直以来国产培养基之路比较崎岖,随着国内部分培养基供应商在培养基的研发及生产方面投入了越来越多的精力,很多优秀的产品也逐渐超越进口品牌成为主流,这也让我们看到了国产品牌的希望。
随着越来越多的国内生物公司通过中美双报,中欧双报走出国门,倒逼国内培养基的研发和制造与国际标准接轨。因此在工艺风险评估中,对培养基进行必要的检测方法能有效保证产品的质量及安全性。
培养基检测方法:
澄清度检查法:澄清度是检查药品溶液的浑浊程度,溶液中如若存在细微颗粒,当直射光通过溶液时,可产生光散射和光吸收的现象,致使溶液微显浑浊,所以澄清度可在一定程度上反映药品的质量和生产工艺水平。
细胞培养基中的营养成分只有完全溶解于水才能被细胞吸收摄取,细胞才能生长增殖,因此培养基是否溶解以及培养液是否透明澄清直接影响培养基使用。通过对水溶解后的培养基的澄清度检查,能够判断细胞培养基的溶解性。此法是用规定级号的浊度标准溶液与供试品溶液比较,以判定细胞培养液的澄清度或其浑浊程度。
pH值测定方法:各种细胞的正常功能及一切生物化学反应,都是在适当和稳定的酸碱环境下进行的,因此细胞培养基的pH值是细胞生长的重要参数,pH值偏低或偏高都会影响细胞生长。
在工业化使用时,由于传统的细胞培养基中含有pH指示剂如酚红等,通常依据“眼睛”观察培养液颜色来判定pH,或是简单的使用pH试纸测定,但是上述方法存在较大的主观因素,影响正确判定,并且在配制的过程中,不同区域还可能存在一定的水质区别等,通过使用pH仪器检测可以消除人的主观判断,准确性更高。此外,在检测过程中,添加碳酸氢钠后的培养基在测定的过程中,暴露在空气中的时间也会对所测pH的准确性有一定的影响。
2020年版《药典》对培养基的要求,应确定每批培养基灭菌后的pH值(冷却至25℃左右测定)。若培养基处方中未列出pH值的范围,除非经验证表明培养基的pH值允许的变化范围很宽,否则,pH值的范围不能超过规定值±02。如需灭菌后进行调整,应使用灭菌或除菌的溶液。
干燥减量测定方法:细胞培养基具有吸湿性,在空气中放置时水分会很快升高,干燥减量表示产品中的含湿量。细胞培养基是有菌制剂,其丰富的营养成分有利于微生物生长,保持培养基中的低水分含量可以有效防止微生物的繁殖。
检测细胞培养基中水分的含量采用的方法是干燥减量法。该测定方法是依据中国药典2010年版二部附录Ⅷ L 干燥失重测定法制定,具体是指产品在规定条件下干燥后所减失重量的百分率。减轻的重量主要是水分、结晶水及其他挥发性物质等。由减失的重量和取样量计算供试品的干燥失重。
渗透压:通常动物细胞必须生活在等渗环境中,借助K+、Na+维持渗透平衡。虽然大多数细胞对渗透压具有有一定的耐受性,但是培养液渗透压过高容易使细胞脱水萎缩,培养液渗透压过低容易使细胞膨胀破裂,控制培养基的渗透压范围对于细胞培养具有重要的作用。
检测通常采用冰点渗透压仪进行,当供试品溶液的毫渗透压摩尔浓度太大或大于仪器的测定范围时,用适宜的溶剂稀释至可测定的毫渗透压摩尔浓度范围。
细菌内毒素检测方法:细菌内毒素是许多病原性细菌所产生的毒素。细胞培养基中细菌内毒素过高,对生物制品的质量如纯度、引起副反应等方面有影响,而且会降低生物制品的产率。
细菌内毒素检查法通常利用鲎试剂来检测或量化由革兰氏阴性菌产生的细菌内毒素,以判断供试品中细菌内毒素的限量是否符合规定的一种方法。其检查包括凝胶法和光度测定法,后者包括浊度法和显色基质法。供试品检测时,可使用其中任何一种方法进行试验。通常当测结果有争议时,以凝胶法结果为准。
微生物限度:细胞培养基不是无菌产品,其中的微生物在一定条件下会吸收培养基中的营养物质滋生繁殖,导致培养基变质失效。控制细胞培养基中细菌和霉菌,是延长培养基有效期的方法之一,对其的检测是非常必要的。
细胞生长实验:细胞在体外进行培养时,失去了机体的调节和控制作用,因此,细胞培养液除满足细胞的营养要求外,还必须使其生存环境接近活体的环境。其中培养液及外环境的培养条件如温度、渗透压、酸碱度等均能影响细胞的生长。
细胞培养基的功能就是满足细胞体外生长增殖需求,因此细胞培养效果的检验是产品质量优劣的一个直观表述,是必检项目,这也是一个产品性能特性表述的要求。
培养基的选择:
选择合适的细胞培养基用于建立上游工艺是生物制剂开发中的重要步骤,作为制药企业等终端培养基用户,可以选择针对自身工艺平台开发定制化培养基,也可以选择现成的商品化培养基。
目前培养基供应商针对不同的细胞培养模式和生产平台,可提供多种商品化培养基供生物工艺开发使用。市场上无血清培养基品牌和种类众多,尤其目前应用最为广泛的治疗性抗体生产的 CHO 细胞培养基。在大规模生产工艺中,在众多选择中筛选合适的培养基是工艺建立的基础。
确定侯选培养基来源及范围:对供应商的现场审核和验证,培养基产品质量,批次稳定性和再现性,价格和客户服务等多种因素决定培养基供应商是否可被接受。选择经过多年市场验证的,知名品牌培养基供应商的商品化培养基,用于初步筛选可以省去此部分调查的人力、资金及时间的投入。更重要的是,可以减少或避免药物申报中的监管风险及保证药物上市后的培养基的供应安全。
培养基性能和表现评估:细胞在不同的生产阶段对营养成分的需求不同,基础培养基通常先要保证细胞接种后能够顺利生长,而有些更利于细胞产物表达的成分可能会对细胞生长具有抑制作用,基础培养基和补料的有机搭配,才能获得最佳细胞生长和表达效果。因此,先筛选出基础培养基,再进行搭配补料的筛选,往往会漏掉非常具有潜力的基础培养基。
用于建立培养工艺的细胞株通常是培养并冻存于某种特定培养基中的,细胞可能会对该培养基中的某些特定成分,或者该培养基的营养成分配比产生依赖,更换至另外的培养基中细胞可能会因为不适应而不能给出客观真实的结果。
将工程细胞克隆适应至候选培养基中是进行培养基筛选的第一步,也是非常重要的一步。细胞适应后是在小规模对这些培养基的培养表现进行评估,比如说单位产量,产品质量、产物稳定性,纯化应用性能和理化性能(例如剪切损伤、泡沫、沉淀,酸碱度控制,代谢废物积累等)。
适应性评估:验证工作可以在能够代表最终生产体系的Scale-down模型上,测试和验证培养基的性能表现、多批次培养基的性能一致性等,必要时还需要测试培养基在生产规模上的性能表现,才能够最终确定培养基。











